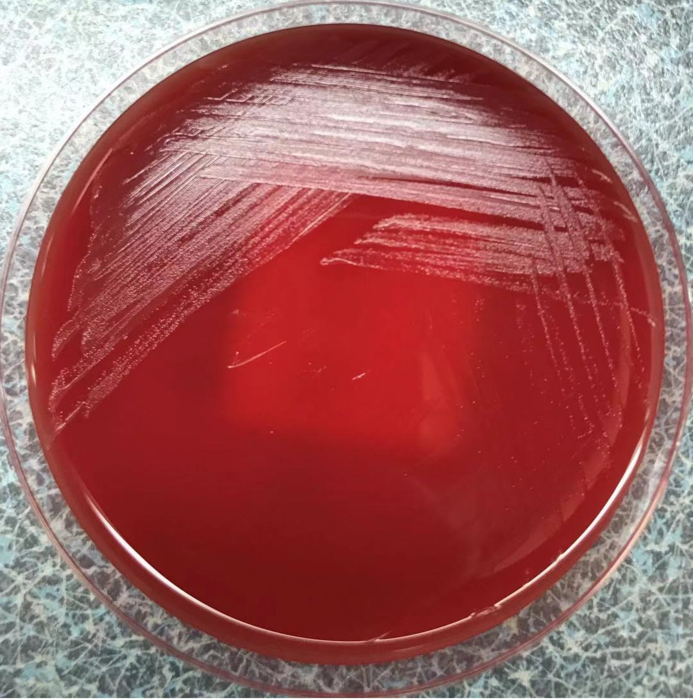
图二:二氧化碳环境孵育48h,第三代培养24h后,出现β溶血现象,再次上机

β溶血环

图二:二氧化碳环境孵育48h,第三代培养24h后,出现β溶血现象,再次上机
图片尺寸681x700
关于β溶血性链球菌转接时没有溶血现象
图片尺寸584x1040
α溶血又称草绿色溶血,在菌落周围可观察到1~2mm的草绿色半透明溶血环
图片尺寸1103x558
每日一菌5
图片尺寸1080x1439
gbs筛查
图片尺寸1198x1224
细菌溶血试验原理及现象
图片尺寸770x682
细菌溶血试验原理及现象
图片尺寸964x616
β溶血性链球菌
图片尺寸512x383
丹毒是一种累及真皮浅层淋巴管的感染,主要致病菌为a组β溶血性链球菌
图片尺寸640x480
连续继代培养后,溶血性减弱或消失,在羔羊血琼脂上可生成双溶血环
图片尺寸708x537
可能涉及到敏感图片,点击后可查看
图片尺寸690x517
图二:二氧化碳环境孵育48h,第三代培养24h后,出现β溶血现象,再次上机
图片尺寸600x480
atcc 25922 10-100cfu 生长良好, β溶血 合格 金黄色葡萄球菌 atcc
图片尺寸300x300
data-lemmaid="7756091">链球菌 /a>常根据其在血琼脂培养基上溶血环
图片尺寸800x600
革兰阳性球菌,如题,如果不做其他鉴定,光看血平板的话像是溶血性
图片尺寸640x1135
整齐,奶油样,瓷白色/浅黄色~橙黄色,有明显β溶血环9315双圈溶血
图片尺寸960x1280
菌落周围形成一个2-4mm宽,界限分明,完全透明的无色溶血环,也称乙型
图片尺寸166x166
溶血环,求解
图片尺寸375x500
图二:二氧化碳环境孵育48h,第三代培养24h后,出现β溶血现象,再次上机
图片尺寸693x700
无乳葡萄球大肠溶血环之分
图片尺寸1080x1080